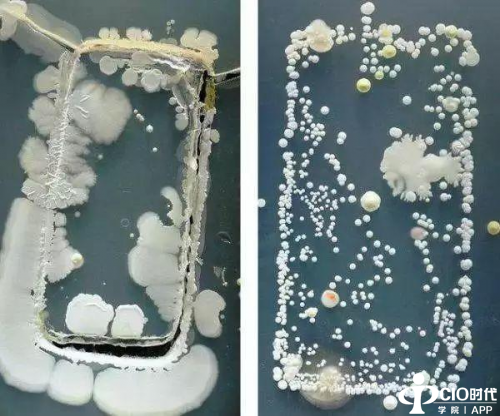

图注:手机表面细菌分布图
4月是流感、病菌滋生的季节,细菌有了温暖的发育条件,开始为祸人间。随时随地紧握在手中的手机就是细菌携带的超级载体,必须抓紧清理手机隐藏的细菌,为自己的健康保驾护航。为了让用户免于手机屏幕细菌的烦恼,极客修4月上线“手机焕新月”的手机清洁活动,在极客修维修中心、商场、影院、校园以及写字楼等地都有极客修工程师开设的“焕新”点位,用户只要拿手机上门,就能够享受免费的手机消毒清洁的服务,更附带免费贴膜的超值福利,让这个春天无菌又洁净。

全国掀起手机清洁热潮 消菌杀毒更干净
自央视进行手机表面细菌的报道后,人们对于手机表面的清洁开始关注起来,尤其在有老人、小孩的家庭,更是将手机清洁视为日常生活的重要任务。正是因为关注到了社会大众对于手机清洁的重视,极客修在全国启动手机清洁的公益活动,所有的用户都可以到极客修享受手机免费清洁的服务,受到大众的广泛好评。
据了解,极客修的活动时间为整个4月份,在这个月内,只要有清洁手机的需求,在极客修就能免费享受保养服务。消毒清洁后的手机将更安全,再也不怕家中的小宝贝拿着手机乱“啃”啦。
手机洁净新标准 无菌更安全
截止目前,仍然有大量用户不知道手机表面隐藏着大量的细菌,对于手机清洁工作也不甚重视。极客修作为手机售后服务的专业性平台,肩负起了向大家普及手机清洁知识的任务,旨在让更多的用户了解手机清洁的意义,制定手机洁净新标准,让用户更好的享受手机带来的便捷。
据了解,细菌分为益生菌、致病菌、过路菌和长居菌几种,其中致病菌就是人们日常生活中应该重点防范的细菌类别。常见的致病菌有肠球菌、大肠杆菌、沙门氏菌等,会直接影响人们的身体健康。尽管目前还没有科学研究表明手机表面隐藏有致病菌,但因为手机长时间与人近距离接触,且有着长期潜伏细菌的风险,人们不能掉以轻心。为什么不在极客修对手机做一个彻底清洁,让你的手机更加干净安全呢。
维修服务新升级 规范助享好口碑
极客修作为新兴的、富有责任感的手机上门服务企业,始终以为用户提供更优质的手机售后服务为己任,力求定制全新的手机维修行业的服务新标准。在这一方面,极客修做出了多番努力:极客修是行业内率先布局上门维修服务的企业,制定了严格的上门服务准则,更同步制定了维修过程全录像,服务完成后付款等服务策略,确保每一次的服务都专业到位。
此外,极客修还是业内首个掀起手机透明维修运动的平台,通过与斗鱼直播平台联合,将维修后台展示在公众面前让大众监督。此外,极客修还开创了首个上门维修服务节,定制了首个维修行业“6S”服务标准,推动行业不断规范化、专业化、系统化和流程化。继3月粉丝福利月后,极客修4月焕新活动紧随而上,力求不断升级用户体验,让用户的售后更安心。
阝月艹帝